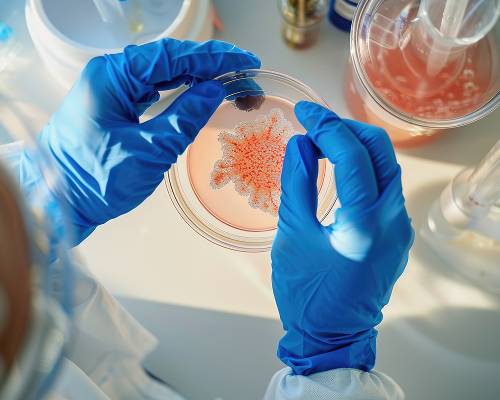
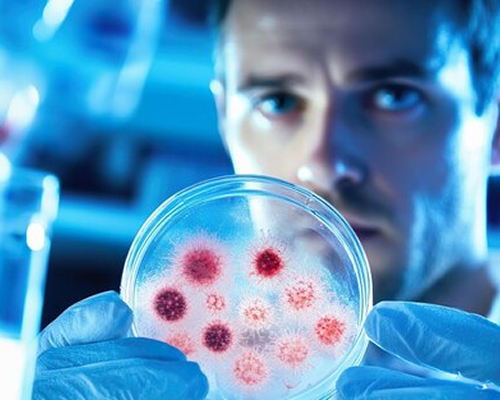

Precision In Diagnosis, Excellence In Care.
We provide accurate insights that guide effective treatments. Visit our clinic today for dependable testing.











Welcome to Suvidha Diagnostic – offering healthcare providers a single source for all their laboratory testing needs in both the primary and specialty health care segments.
Suvidha Diagnostic is full service clinical diagnostic laboratory in Gujarat, India. Providing testing and related services to physician offices, clinics, hospitals, long term care facilities, employers, governmental units and correctional institutions.

MBBS, from B. J Medical College MD in Pathology & D.C.P. from NHL Medical College.

MBBS, MD in Pathology & D.C.P. from NHL Medical College, Expert in Clinical Pathology.
Clinical Pathology focuses on the laboratory analysis of blood, urine, body fluids, and other clinical samples to detect diseases, monitor health conditions, and support accurate treatment decisions. Using advanced diagnostic techniques and modern laboratory equipment, our clinical pathology services deliver precise, reliable, and timely test results for comprehensive patient care.
Our laboratory performs a wide range of routine and specialized investigations with a strong emphasis on accuracy, quality control, and fast reporting.
Read More
Biochemistry focuses on analyzing blood and body fluid components to evaluate organ function, detect diseases, and monitor overall health. Through advanced biochemical testing, we help identify conditions related to liver, kidney, thyroid, diabetes, lipid disorders, and other metabolic abnormalities with precision and reliability.
Our laboratory offers a wide range of routine and specialized biochemistry investigations using modern analyzers and strict quality control standards. Each test is performed with accuracy and efficiency to support early diagnosis, preventive screening, and effective treatment planning for better patient care.
Read More
Histopathology focuses on the microscopic examination of tissues to detect abnormalities, diagnose diseases, and support accurate treatment decisions. It plays a vital role in identifying infections, inflammatory conditions, tumors, and various benign or malignant disorders through detailed tissue analysis.
Our histopathology laboratory uses advanced techniques and precise staining methods to evaluate biopsy and surgical specimens with high accuracy. Every sample is carefully processed and examined to provide reliable diagnostic insights that assist doctors in early detection, disease assessment, and personalized treatment planning.
Read More
Endocrinology focuses on diagnostic testing related to hormones and endocrine glands to detect, monitor, and manage hormonal imbalances and metabolic disorders. These tests play an important role in evaluating thyroid function, diabetes, reproductive hormones, adrenal disorders, and other endocrine conditions.
Our laboratory provides comprehensive endocrinology testing using advanced diagnostic methods and high-precision analyzers to ensure accurate and reliable results. From routine hormone screening to specialized endocrine investigations, each test supports early diagnosis, treatment monitoring, and effective clinical decision-making.
Read More
Immunohistochemistry (IHC) is an advanced diagnostic technique used to identify specific proteins and markers within tissue samples, helping in the accurate diagnosis and classification of various diseases, especially cancers. It plays a crucial role in detecting tumor types, determining disease progression, and supporting targeted treatment decisions. Our laboratory performs immunohistochemistry testing using advanced staining methods and modern diagnostic technology to deliver precise and reliable results.
Each sample is carefully analyzed to provide detailed insights that assist clinicians in diagnosis, prognosis evaluation, and personalized therapy planning.
Read More
Serology focuses on the detection and analysis of antibodies, antigens, and immune responses in blood samples to help diagnose infections, autoimmune disorders, and various immune-related conditions. It plays an important role in disease screening, monitoring infections, and supporting accurate clinical diagnosis.
Our laboratory offers a wide range of serological tests using advanced diagnostic methods and modern technology to ensure precise and reliable results.
Read More
Hematopathology focuses on the study and diagnosis of disorders related to blood, bone marrow, and lymphatic tissues. It plays a crucial role in identifying anemia, infections, clotting disorders, leukemia, lymphoma, and other hematological conditions through specialized laboratory analysis.
Our laboratory provides comprehensive hematopathology testing using advanced diagnostic techniques and modern equipment to ensure accurate and reliable results. From routine blood evaluations to specialized investigations, each sample is carefully analyzed to support early diagnosis, disease monitoring, and effective treatment planning.
Read More
Flow Cytometry is an advanced diagnostic technique used to analyze and measure the characteristics of cells, including their size, structure, and specific markers. It plays a vital role in diagnosing blood disorders, immune deficiencies, leukemias, lymphomas, and monitoring various complex medical conditions.
Our laboratory offers specialized flow cytometry testing using advanced technology and high-precision instruments to provide accurate and reliable cellular analysis. Each sample is carefully evaluated to support disease diagnosis, treatment monitoring, and detailed clinical assessment with dependable results.
Read More
Cytogenetics focuses on the study of chromosomes to detect genetic abnormalities, inherited disorders, and chromosomal changes associated with various diseases. It plays a crucial role in diagnosing genetic conditions, prenatal abnormalities, infertility issues, and certain cancers through specialized chromosome analysis. Our laboratory provides advanced cytogenetic testing using modern diagnostic techniques and precise laboratory methods to deliver accurate and reliable results.
Each sample is carefully analyzed to identify chromosomal variations that support early diagnosis, disease evaluation, and effective treatment planning.
Read More
Microbiology focuses on the detection and analysis of bacteria, viruses, fungi, and other microorganisms to diagnose infections and support effective treatment decisions. It plays a vital role in identifying infectious diseases, monitoring microbial growth, and guiding appropriate therapy through precise laboratory testing.
Our laboratory offers comprehensive microbiology testing using advanced diagnostic techniques and modern equipment to ensure accurate and reliable results.
Read More
Toxicology focuses on the detection and analysis of toxic substances, drugs, chemicals, and poisons to support accurate diagnosis and effective treatment decisions. It plays a vital role in identifying toxic exposures, monitoring substance levels, and evaluating poisoning cases through specialized laboratory investigations.
Our laboratory offers comprehensive toxicology testing using advanced diagnostic methods and modern analytical technology to ensure precise and reliable results.
Read More
Reports Delivered
Accurate Test Results
Tests Successfully Done
Quick and easy patient registration with basic details collection.
Safe and hygienic sample collection performed by trained staff.
Advanced laboratory testing ensuring accurate and reliable results.
Fast and secure report delivery available online or in print.


We provide advanced diagnostic services with a focus on accuracy, speed, and patient care. Our expert team and modern laboratory ensure every test delivers reliable results you can trust.
Modern equipment ensures precise and accurate testing.
Skilled professionals deliver reliable diagnostic results.
Quick report delivery with complete accuracy and trust.
I have done my blood test reports and the staff came to my home to collect the sample. The staff is very polite and the service is also & best good.
We always prefer Suvidha lab for any kind of blood test , they have well experienced staff who smoothly take a sample . Today we have booked blood test for Surbhi Jani !!
Fastest service and quality reporting. I have used several labs in past but noone can come close to the quality service Suvidha's team provides.
Best and accurate pathology laboratory and diagnostics centre in Ahmedabad. Done body profile check up. Staff was well experienced and cooperative.
Accurate reports. Very good pathology laboratory in Ahmedabad. Done body checkup for my parents. Staff was helpful and experienced.
Advanced Care • Trusted Experts